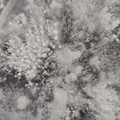

Abraham Lake
33
1106
-
Abraham Lake 瀏覽44 推薦0
-
Abraham Lake 瀏覽36 推薦0
-
Abraham Lake 瀏覽38 推薦0
-
Abraham Lake 瀏覽40 推薦0
-
Abraham Lake 瀏覽46 推薦0
-
Abraham Lake 瀏覽48 推薦0
-
Abraham Lake 瀏覽48 推薦0
-
Abraham Lake 瀏覽55 推薦0
-
Abraham Lake 瀏覽52 推薦0
-
Abraham Lake 瀏覽47 推薦0
-
Abraham Lake 瀏覽42 推薦0
-
Abraham Lake 瀏覽37 推薦0
-
Abraham Lake 瀏覽35 推薦0
-
Abraham Lake 瀏覽37 推薦0
-
Abraham Lake 瀏覽36 推薦0
-
Abraham Lake 瀏覽32 推薦0
-
Abraham Lake 瀏覽36 推薦0
-
Abraham Lake 瀏覽32 推薦0
-
Abraham Lake 瀏覽35 推薦0
-
Abraham Lake 瀏覽31 推薦0









